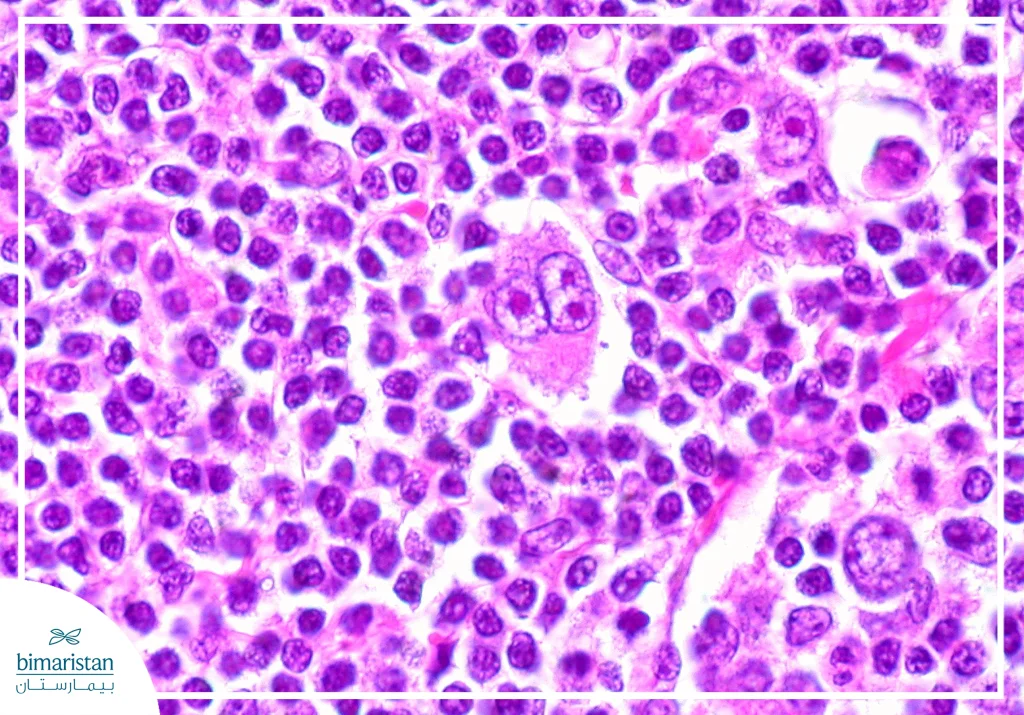
لمفوما هودجكن: الدليل الطبي الشامل من التشخيص للعلاج 6 صورة توضح خلايا ريد – ستيرنبرغ التي تميز لمفوما هودجكن

تُعدّ لمفوما هودجكن أحد أهم سرطانات الدم والجهاز اللمفي وأكثرها قابلية للعلاج في الطب الحديث، حيث تنشأ من تحوّل خبيث يصيب الخلايا اللمفاوية المسؤولة عن الدفاع المناعي في الجسم. وعلى الرغم من أن كلمة سرطان قد تثير القلق، فإن التقدّم الكبير في وسائل التشخيص النسيجي والتصوير المرحلي والعلاج الكيميائي والمناعي والموجّه جعل نسب الشفاء في هذا المرض مرتفعة بشكل ملحوظ، خاصةً عند الكشف المبكر ووضع خطة علاجية دقيقة.
لمحة عن الجهاز اللمفي والخلايا اللمفاوية
يتكون الجهاز اللمفاوي من:
- اللمف
- الأوعية اللمفاوية
- العقد اللمفاوية
- نقي العظم
- الطحال
- الغدة الزعترية (التيموس)
- اللوزات
- النسيج اللمفي المرتبط بالأغشية المخاطية

الخلايا اللمفاوية
- اللمفاويات البائية: تنضج في نقي العظم وتنتج الأجسام المضادة.
- اللمفاويات التائية: تنضج في التيموس وتشارك في المناعة الخلوية.
تُعرَّف هذه الخلايا بواسطة واسمات سطحية (CD markers)، مثل CD20 و CD45 وهي مهمة جداً في التشخيص والعلاج الموجّه.
ما هي اللمفوما (Lymphoma)؟
اللمفوما هي ورم خبيث يصيب الخلايا اللمفاوية (نوع من الكريات البيضاء) وينشأ نتيجة طفرات جينية مكتسبة تؤدي إلى:
- تكاثر خلوي غير مضبوط
- مقاومة الموت الخلوي المبرمج
- تراكم الخلايا الورمية داخل العقد اللمفاوية أو الأعضاء اللمفية أو خارجها
تستطيع الخلايا الورمية الانتقال عبر الدم والجهاز اللمفي لتصيب العقد اللمفاوية والطحال ونقي العظم وأعضاء أخرى. وتصنف اللمفوما بشكل أساسي إلى لمفوما هودجكن ولمفوما لاهودجكين ويختلف كل منهما جذرياً من حيث السلوك الحيوي والخزعة النسيجية والاستجابة العلاجية، لذلك يُعدّ تحديد النوع بدقة خطوة محورية في الخطة العلاجية.
ما هو سرطان لمفوما هودجكن؟
لمفوما هودجكن هو ورم خبيث لمفاوي يتميز بوجود خلايا نوعية مميزة تدعى خلايا ريد – ستيرنبرغ وتتميز بأنها:
- كبيرة الحجم
- متعددة الأنوية
- تعطي مظهر عين البومة
- تنشأ غالباً من خلايا بايئية متحولة
تفرز هذه الخلايا سيتوكينات تجذب خلايا التهابية حولها وهو ما يفسر تضخم العقد اللمفاوية.
عوامل الخطورة للإصابة بلمفوما هودجكن
السبب الدقيق لا يزال معروف بشكل حاسم، ولكن تتضمن عوامل الخطورة ما يلي:
- الإصابة السابقة بفيروس فيروس إبشتاين – بار
- ضعف المناعة مثل فيروس نقص المناعة البشرية
- الأدوية المثبطة للمناعة
- قصة عائلية إيجابية
- بعض العوامل البيئية أو الوراثية المحتملة
الأعراض والعلامات السريرية للمفوما هودجكن
هناك بعض الأعراض الموضعية مثل وجود تضخم غير مؤلم في العقد اللمفاوية (العنقية والإبطية والمنصفية)، وهناك أيضاً بعض الأعراض الجهازية (أعراض B) مثل:
- حمى غير مفسرة
- تعرق ليلي غزير
- فقدان وزن >10% خلال 6 أشهر
وقد تترافق مع بعض الأعراض الإضافية مثل:
- تعب شديد
- حكة جلدية
- ألم العقد بعد تناول الكحول
- سعال أو ضيق نفس عند وجود كتلة منصفية
الفرق بين لمفوما هودجكن ولاهودجكين
جدول يوضح الفرق بين لمفوما هودجكن ولاهودجكين:
| الخاصية | هودجكن | لا هودجكن |
| خلايا ريد–ستيرنبرغ | موجودة | غير موجودة |
| الانتشار | عقدي متسلسل | غير منتظم وخارج عقدي غالباً |
| الاستجابة للعلاج | ممتازة غالباً | متغيرة |
أنواع لمفوما هودجكن؟
عندما نأخذ خزعة من العقدة اللمفاوية ونفحصها تحت المجهر مع فحوص مناعية خاصة، نلاحظ:
- شكل الخلايا الورمية (خصوصاً خلايا ريد–ستيرنبرغ)
- نوع الخلايا الطبيعية المحيطة بها (لمفاويات أو حمضات أو عدلات)
- وجود تليف أو بنية عقدية
- الواسمات المناعية على سطح الخلايا
وهو ما يحدد النوع النسيجي الذي يساعدنا في فهم سلوك المرض (انتشاره وشدته) وتقدير الإنذار واختيار أفضل بروتوكول علاجي حيث أن العلاج الأساسي غالباً متشابه بين الأنواع، ولكن النوع النسيجي يؤثر على طريقة التقييم والمتابعة وخيارات بعض الحالات الخاصة.
لمفوما هودجكن الكلاسيكية
تسمى كلاسيكية لأنها الشكل الأكثر شيوعاً وتمثل تقريباً 90–95% من الحالات ولها صفات ثابتة، تتميز بوجود واسمات:
- CD30 إيجابي
- CD15 إيجابي
- CD20 سلبي أو ضعيف
- CD45 سلبي
وجود CD15 وCD30 يساعد الطبيب ويؤكد أن هذا الشكل هو الكلاسيكي.
تتشمن لمفوما هودجكن الكلاسيكية تحت أنواع وهي:
التصلّب العقدي
الأكثر شيوعاً وبشكل خاص عند الشباب حيث نرى في الخزعة ما يلي:
- بنية عقدية
- حواجز ليفية تقسم العقدة إلى عُقيدات
- نوع خاص من خلايا ريد–ستيرنبرغ يسمى Lacunar cells تبدو كأنها داخل فراغ
- يظهر كثيراً في الصدر وقد يسبب سعال وضيق نفس إذا كان كبيراً
- يكون الإنذار جيد جداً لأن هذا النوع يستجيب للعلاج بشكل ممتاز
لمفوما هودجكن الكلاسيكية الخلوية المختلطة
يكون المشهد النسيجي مختلط بسبب وجود خلايا مناعية عديدة ومتنوعة حول الخلايا الورمية. نرى في الخزعة رشاحة التهابية غنية تضم لمفاويات وحمضات وعدلات وخلايا بلعمية وخلايا ريد–ستيرنبرغ واضحة. يُشاهد أكثر عند كبار السن أو في حال وجود نقص في المناعة، وقد يرتبط أكثر بفيروس EBV مقارنةً بالنوع العقدي المتصلب. يكون الإنذار جيد إلى متوسط حسب المرحلة والانتشار.
لمفوما هودجكن الكلاسيكية الغنية باللمفاويات
أغلب الخلايا الموجودة في الخزعة هي لمفاويات طبيعية والخلايا الورمية قليلة. حيث نرى:
- لمفاويات كثيرة جداً
- خلايا ريد–ستيرنبرغ قليلة
- شكل التهابي هادئ نسبياً
يكون الإنذار غالباً ممتاز ويعد من أفضل الأنواع ضمن لمفوما هودجكن الكلاسيكية.
لمفوما هودجكن الكلاسيكية الفقيرة باللمفاويات
هذا النوع هو الأندر ضمن لمفوما هودجكن الكلاسيكية، لكنه الأكثر شراسة وصاحب أسوأ إنذار، حيث نرى:
- لمفاويات قليلة جداً
- خلايا ورمية كثيرة نسبياً
- أحياناً تليف أو تنخر بحسب الحالة
يشاهد غالباً في حالات متقدمة أو عند ضعف مناعة شديد، لذلك يكون الإنذارغالباً سيء.
النمط العقدي الغني بالخلايا اللمفاوية
يختلف عن النمط الكلاسيكي لأنه يعتبر أقل شيوعاً (حوالي 5–10% تقريباً) ويختلف في الخلايا الورمية والواسمات المناعية وغالباً ما يكون سلوكه أبطأ. الخلايا الورمية هنا تُسمى LP cells (Lymphocyte Predominant cells) وتبدو نواتها متعرجة وكبيرة مثل حبة الفشار لذلك تسمى Popcorn cells. تكون غالباً:
- CD20 إيجابي
- CD45 إيجابي
- CD15 سلبي
- CD30 سلبي
يتظاهر النمط العقدي الغني بالخلايا اللمفاوية سريرياً بتضخم عقد لمفاوية موضعي، تكون أعراض B أقل حدوثا، وكثيراً ما يكون في مراحل أبكر. يكون الإنذار جيد جداً في الغالب ولكن قد يحدث نكس متكرر عند بعض المرضى (حتى بعد سنوات).
تشخيص لمفوما هودجكن
تتضمن الخطوات الأساسية للتشخيص:
- القصة المرضية والفحص السريري
- CBC
- ESR و LDH
- تصوير CT وPET-CT
- تحري فيروسات (HIV, HBV, HCV)
- الخزعة العقدية الجراحية (وهي المعيار الذهبي)
- خزعة نقي العظم عند الاشتباه بالانتشار
لا يُنصح بالشفط بالإبرة الدقيقة وحدها لأنها غير كافية للتشخيص.
التصنيف المرحلي
يستخدم تصنيف لوغاني الذي يتضمن:
- المرحلة I: عقدة واحدة
- المرحلة II: عقد متعددة على نفس جانب الحجاب الحاجز
- المرحلة III: على جانبي الحجاب الحاجز
- المرحلة IV: انتشار لأعضاء بعيدة (الكبد/الرئة/نقي العظم)

علاج لمفوما هودجكن
يتضمن علاج لمفوما هودجكن عدة أشكال علاجية
العلاج الكيميائي
إن العلاج الكيميائي هو العلاج الأساسي لأن خلايا لمفوما هودجكن تكون سريعة الانقسام وحساسة جداً للأدوية السامة للخلايا، لذلك فإن العلاج الكيميائي هو الملجأ الأول في جميع المراحل تقريباً. إن البروتوكول الأكثر استخداماً هو نظام ABVD الذي يتكون من 4 أدوية، وهي:
- دوكسوروبيسين (Adriamycin): يثبط تصنيع DNA وهو شديد الفعالية ضد الخلايا الورمية، تعد السمّية القلبية أحد أهم مضاعفاته.
- بليومايسين: يساعد في حدوث تكسرات في DNA، تعد السمّية الرئوية أحد أهم مضاعفاته.
- فينبلاستين: يثبط الانقسام الخلوي
- داكاربازين: عامل ألكلة (Alkylating agent) يوقف تضاعف الخلايا
قد تُستخدم في بعض الحالات BEACOPP (للحالات عالية الخطورة) أو A+AVD (يستبدل البليومايسين بـ برينتوكسيماب). يُعطى العلاج وريدياً على شكل دورات لأن الخلايا السرطانية تموت والجسم يحتاج وقتاً للتعافي (نقي العظم والمناعة)، تكون كل دورة تقريباً لمدة أسبوعين وعدد الدورات يكون في الحالات المبكرة من 2 إلى 4 دورات، أما في الحالات المتقدمة فيكون عدد الدورات 6 فأكثر.
الآثار الجانبية للعلاج الكيميائي
قد يترافق العلاج الكيميائي للمفوما هودجكن بما يلي:
- تساقط الشعر
- غثيان/إقياء
- نقص الكريات البيضاء (خطر العدوى)
- فقر دم
- تعب
- سمّية قلبية (دوكسوروبيسين)
- سمّية رئوية (بليومايسين)
لذلك يجب أن نراقب وظائف القلب ووظائف الرئة وتعداد الدم
العلاج الشعاعي
لا يكون العلاج الشعاعي لكل المرضى ويُستخدم غالباً:
- في المراحل المبكرة
- بعد العلاج الكيميائي
- عند وجود كتلة كبيرة موضعية
- للقضاء على بقايا المرض
يعتمد العلاج الإشعاعي على أشعة عالية الطاقة تكسر DNA الخلايا الورمية وتؤدي لموتها. يتميز بأنه يقلل النكس الموضعي ويرفع نسب الشفاء، مخاطره بعيدة المدى تتضمن قصور الغدة الدرقية وأمراض قلبية وسرطانات ثانوية وتليف رئوي، لذلك نستخدم جرعات أقل وتقنيات حديثة دقيقة.
العلاج المناعي
هو مهم جداً في علاج لمفوما هودجكن لأن خلايا الورم تعبر عن PD-L1 لتخدع الخلايا المناعية وتوقفها، فيقوم العلاج المناعي بكسر هذه الحيلة. تتضمن مثبطات PD-1النيفولوماب والبيمبروليزوماب التي تمنع ارتباط PD-1 مع PD-L1 وتعيد تنشيط الخلايا التائية مما يحفز المناعة كي تهاجم الورم، نلجأ للعلاج المناعي في حالات:
- المرض الناكس
- المقاومة للعلاج الكيميائي
- بعد الزرع
- أو عند المرضى غير القادرين على الخضوع للعلاج الكيميائي
يتميز العلاج المناعي بفعالية ممتازة وسمّية أقل من العلاج الكيميائي ونوعية حياة أفضل. وترتبط آثاره الجانبية غالباً بفرط المناعة مما يعرض المريض لـ:
- التهاب درقي
- التهاب قولون
- التهاب رئة
- طفح جلدي
هذه الحالات غالباً تكون قابلة للعلاج بالكورتيزون.
العلاج الموجه للمفوما هودجكن
مثل برينتوكسيماب فيدوتين وهو جسم مضاد ضد CD30 ملتصق بدواء سام للخلايا يصل مباشرة للخلايا الورمية فقط، يقلل أذية الخلايا الطبيعية وهو أكثر دقة من العلاج الكيميائي، يتم اللجوء إليه في حالات:
- العلاج الكيميائي في الخط الأول لبعض المرضى
- في النكس
- بعد الزرع
تتضمن آثاره الجانبية اعتلال أعصاب محيطية وتعب وغثيان خفيف.
زرع الخلايا الجذعية
نلجأ له عند المرض الناكس وعدم الاستجابة للعلاج الكيميائي أو المرض عالي الخطورة، قد يحقق الشفاء حتى بعد فشل العلاجات الأخرى حيث نقوم بإعطاء جرعات كيميائية عالية جداً تقتل كل الخلايا الورمية وتدمر نقي العظم، فنعيد زرع خلايا جذعية لاستعادة إنتاج الدم. تتضمن أنواعه النمط الذاتي وهو الأكثر استخداماً والنمط الخيفي (من متبرع) في حالات محدودة، تشمل زرع الخلايا الجذعية بعض المخاطر مثل حدوث:
- عدوى شديدة
- نزف
- مضاعفات مناعية
متى يجب مراجعة الطبيب؟
يجب على المريض مراجعة الطبيب بشكل عاجل وفوري عند ظهور أي من الصفات التالية:
- تضخم عقد لمفاوية لأكثر من 2–3 أسابيع
- حمى أو تعرق ليلي أو نقص وزن غير مفسر
- ضيق نفس أو ألم صدري
التقييم المبكر يرفع فرص الشفاء بشكل كبير.
يُعتبر سرطان لمفوما هودجكن مثالاً واضحاً على التطور الكبير في طب الأورام الحديث، إذ تحوّل من مرض مهدِّد للحياة إلى سرطان يتمتع بمعدلات شفاء مرتفعة وفرص بقاء ممتازة عند التشخيص المبكر والعلاج المناسب. ويعتمد النجاح العلاجي على التكامل بين الخزعة الدقيقة والتصنيف المرحلي الصحيح واختيار البروتوكول العلاجي الأنسب سواءً بالعلاج الكيميائي أو الشعاعي أو المناعي أو الموجّه وفي بعض الحالات زرع الخلايا الجذعية.
المصادر:
- National Health Service. (n.d.). Hodgkin lymphoma. NHS.
- Cancer Research UK. (n.d.). Hodgkin lymphoma. Cancer Research UK.
- Macmillan Cancer Support. (n.d.). Hodgkin lymphoma. Macmillan.
- Swerdlow, S. H., Campo, E., Pileri, S. A., et al. (2017). Hodgkin lymphoma. In J. W. Wilson, D. T. Shlomchik, & E. Campo (Eds.), Non-Hodgkin Lymphoma and Hodgkin Lymphoma (pp. – ). National Center for Biotechnology Information.
- Blood Cancer United. (n.d.). Hodgkin lymphoma. Blood Cancer United.
